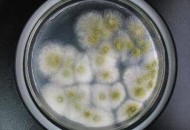
知名品牌菌落超48倍,菌落大全

当前位置:首页
>> 知名品牌菌落超48倍
-
网络资讯知名品牌菌落超48倍,菌落大全大家好,今天小编关注到一个比较有意思的话题,就是关于知名品牌菌落超48倍的问题,于是小编就整理了1个相关介绍知名品牌菌落超48倍的解答,让我们一起看看吧。菌落计...发布时间:2025年11月25日立即查看
网络资讯知名品牌菌落超48倍,菌落大全大家好,今天小编关注到一个比较有意思的话题,就是关于知名品牌菌落超48倍的问题,于是小编就整理了1个相关介绍知名品牌菌落超48倍的解答,让我们一起看看吧。菌落计...发布时间:2025年11月25日立即查看 -
 网络资讯知名品牌菌落超48倍,菌落计数器哪个牌子的好用,不容易坏?大家好,今天小编关注到一个比较有意思的话题,就是关于知名品牌菌落超48倍的问题,于是小编就整理了1个相关介绍知名品牌菌落超48倍的解答,让我们一起看看吧。菌落计...发布时间:2025年11月24日立即查看
网络资讯知名品牌菌落超48倍,菌落计数器哪个牌子的好用,不容易坏?大家好,今天小编关注到一个比较有意思的话题,就是关于知名品牌菌落超48倍的问题,于是小编就整理了1个相关介绍知名品牌菌落超48倍的解答,让我们一起看看吧。菌落计...发布时间:2025年11月24日立即查看

